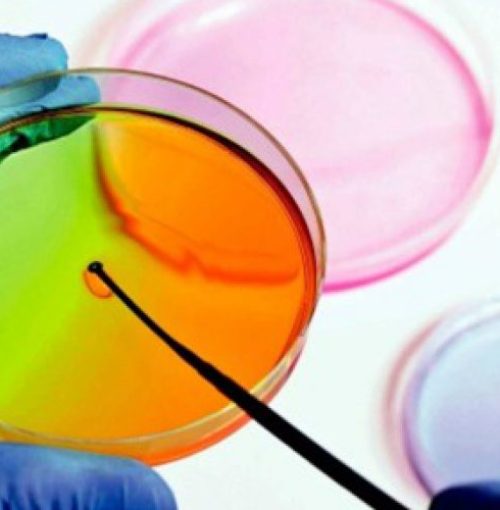
P144618

TÍTULO: “Actividad antimicrobiana de aceites esenciales de plantas de la región de cuyo, en alimentos perecederos.”
PROIPRO 14-4618
Resumen
La preservación o conservación de los alimentos frente al ataque de los agentes biológicos externos que causan su deterioro, ha sido y es necesaria para la humanidad desde la antigüedad ya sea con fines de supervivencia como de índole económica. Existe actualmente un número elevado de métodos de conservación de alimentos de acuerdo a su naturaleza física y química. Dentro de los métodos de control químico el uso de productos de origen vegetal ya sean extractos, oleorresinas y aceites esenciales se ha propagado muchos en los últimos años, especialmente debido a que los consumidores los consideran como productos naturales libres de efectos secundarios.Las actividades antimicrobianas de los aceites esenciales y de sus componentes son conocidas desde la antigüedad. Los extractos acuosos están constituidos por moléculas polares solubles en agua, en tanto los aceites esenciales están constituidos por mezclas complejas de moléculas volátiles, que son producidos por el metabolismo secundario de plantas aromáticas, medicinales y pueden ser obtenidos mediante distintas técnicas de extracción desde las diferentes partes de las plantas. El amplio número de estudios realizados sobre la actividad antimicrobiana de los aceites esenciales, ha permitido el reconocimiento científico de estos compuestos sobre el control de una amplia gama de patógenos microbianos. Los progresos realizados en la investigación del modo de acción de los aceites esenciales contra las células bacterianas, permiten plantear nuevas perspectivas para combatir los microorganismos patógenos resistentes o refractarios a los antimicrobianos actuales. La dilucidación de los mecanismos de los aceites esenciales, permitirá dosificar las concentraciones de uso, disminuyendo los potenciales efectos secundarios en su uso como agentes conservantes de alimentos. El objetivo de este proyecto es contribuir al entendimiento del mecanismo de acción de los aceites esenciales sobre los microorganismos y dilucidar y evaluar en forma cualitativa y cuantitativa su mecanismo de acción mediantes ensayos de rutina microbiológica y de Biología Molecular, su actividad frente a cepas con conocida actividad perjudicial sobre alimentos.
Director
Roberto CARRIZO FLORES
focarrizo@unsl.edu.ar
VENCIMIENTO
AÑO: 2019
